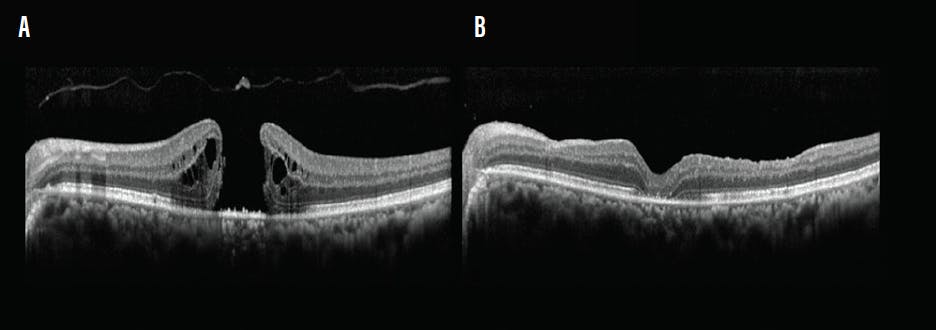
<p>Figure 2. Idiopathic macular hole. Preoperative OCT of a 65-year-old woman shows a large full-thickness macular hole with cystoid spaces (A). At 1 month postoperative, OCT shows a type 1 closure (B).</p>
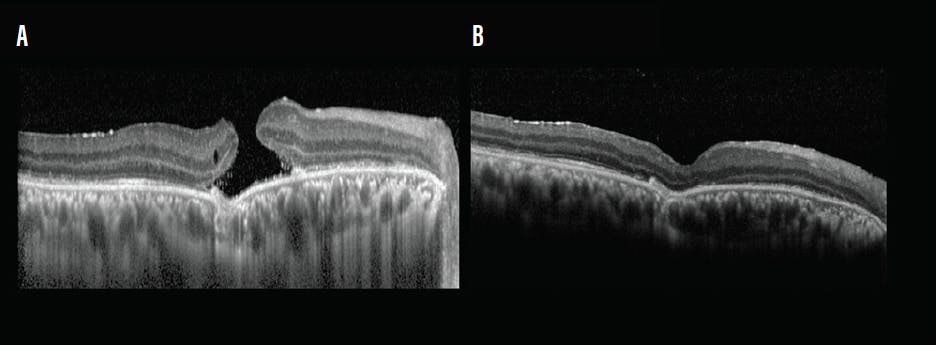
<p>Figure 3. Traumatic macular hole. Preoperative OCT of a 40-year-old man shows a traumatic macular hole (A). At 1 month postoperative, OCT shows anatomic closure of the hole (B).</p>

AT A GLANCE
- The Retinal Massager (RM) is a tool for safely treating large full-thickness macular holes.
- After core vitrectomy and ILM peeling, the tool is used to massage the edges of the hole.
- The RM enhances the closure rate in large macular holes.
Macular hole surgery is one of the most common indications for vitrectomy. The gold standard procedure in the treatment of macular holes include pars plana vitrectomy, induction of posterior vitreous detachment, peeling of the internal limiting membrane (ILM), complete fluid-gas exchange, and facedown positioning postoperatively.
Reported anatomic success rates for macular hole surgery range from 93% to 98%.1-4 By contrast, reported anatomic success rates for large macular holes range from 70% to 90%.5,6
Several adjuncts to the conventional procedure have been described to aid in the closure of large holes, including inverted ILM flap, free ILM flap, autologous lens capsular flap, and neurosensory retinal flap.7-10
In our own approach to macular hole surgery, we have been gently massaging the edges of the macular hole after ILM peeling using the tip of forceps or the edges of the vitreous cutter to help with approximation of the edges. Following fluid-air exchange, usually the holes would close or decrease in size on the table. However, forceps and cutter are not ideal instruments for this maneuver, as they have irregular edges that could be traumatic to the surface of the retina.
To facilitate our massaging technique, we have devised a new instrument, the Retinal Massager (RM, Epsilon).
DESIGN
Designed for 25-gauge vitreous surgery, the RM has a 37-mm–long titanium shaft with a handle (Figure 1). The smooth bulbous tip at the end of the shaft is designed to be atraumatic to the retinal surface. Its shape resembles a miniature version of an external indenter. Its clinical application in macular hole surgery is to facilitate approximating the edges of the hole.

Figure 1. The Retinal Massager (RM) is a 25-gauge titanium instrument with a 37-mm shaft and a handle. The smooth bulbous tip at the end of the shaft is designed to be atraumatic to the retinal surface.
We have used the RM in treatment-naive patients with large full-thickness macular holes (>600 µm in diameter) as measured with the caliper function on OCT.
SURGICAL TECHNIQUE
The instrument is used during standard 25-gauge pars plana vitrectomy. A posterior vitreous detachment is induced using a vitreous cutter, with triamcinolone acetonide injection to enhance visualization. After the vitreous is cleared, brilliant blue G dye (Ocublue Plus, Aurolab) is injected over the macular area to stain the ILM. The stained ILM is pinched with 25-gauge end-gripping forceps (Grieshaber, Alcon) and peeled off in a circular fashion, using a pinch-and-peel technique, to approximately 2 disc diameters around the hole.
The RM is then used to gently massage the edges of the macular hole. The rounded tip of the instrument is massaged over the edges in an outside-in direction along the entire circumference of the hole. The surrounding edges of the macular hole tend to be relaxed by this maneuver, and the overall size of the hole becomes smaller.
Fluid-air exchange is performed, and the fluid is aspirated over the area of the macular hole. The hole is visibly smaller at this stage, almost a pinpoint. Peripheral retina is thoroughly screened for any residual vitreous or iatrogenic breaks. C3F8 gas is then injected followed by postoperative facedown positioning.
Preoperative and postoperative OCT are used to assess the anatomic outcomes of surgery, and BCVA and microperimetry are used to evaluate functional outcomes at 1 month follow-up. Anatomic closure on OCT is defined as the approximation of the edges of the hole with resolution of the subretinal cuff of fluid.
Because the maneuver involves contact with the retinal surface, we have used the MP-3 Microperimeter (Nidek) to assess changes in retinal sensitivity in areas where the massaging was done, looking for any reduction in sensitivity. Scans were obtained preoperatively and 1 month postoperatively.
SURGICAL OUTCOMES
At the time of this writing, we have used the RM 45 in patients with large full-thickness macular holes. Mean BCVA (logMAR) improved from 0.6 preoperatively to 0.4 postoperatively. Macular hole closure was observed in 93.3% (42 of 45) of patients. On OCT imaging, type 1 closure was observed at 1 month postoperative in all cases (Figures 2 and 3).
Figure 2. Idiopathic macular hole. Preoperative OCT of a 65-year-old woman shows a large full-thickness macular hole with cystoid spaces (A). At 1 month postoperative, OCT shows a type 1 closure (B).
Figure 3. Traumatic macular hole. Preoperative OCT of a 40-year-old man shows a traumatic macular hole (A). At 1 month postoperative, OCT shows anatomic closure of the hole (B).
Comparing microperimetry scans, we observed that retinal sensitivity in the area of the macular hole improved following closure of the hole in all our patients. Our main focus was on the circumferential area around the hole where the RM was used, and we found that the retinal sensitivity in preoperative and postoperative scans was almost identical, indicating that the act of massaging did not have detrimental effects on retinal sensitivity (Figure 4).

Figure 4. Fundus photography shows retinal sensitivity using microperimetry. Preoperative scans of a 60-year-old patient show reduced sensitivity in the foveal area corresponding to a macular hole. The retinal sensitivity in the parafoveal area where the RM would be used can be noted (A). At 1 month postoperative, scans show almost identical retinal sensitivity in the parafoveal area, indicating that the act of massaging did not cause detrimental effects on retinal sensitivity. Also, the retinal sensitivity in the foveal area has improved corresponding to hole closure (B).
CONCLUSION
Aside from macular hole surgeries, we have also used the RM in surgery for proliferative vitreoretinopathy. In these surgeries, the device aids in ironing out stiff retinal folds and helps unfold the stiff rolled-over edges of large tears (Video, ).
The RM is an efficient adjunct to standard macular hole surgery to enhance anatomic and functional outcomes in surgeries for large macular holes. Postoperative retinal imaging with OCT and functional assessment with microperimetry can help to elucidate the efficacy and safety of this surgical tool and technique.
1. Rahimy E, McCannel CA. Impact of internal limiting membrane peeling on macular hole reopening. A systematic review and meta-analysis. Retina. 2016;36:679-687.
2. Lai MM, Williams GA. Anatomical and visual outcomes of idiopathic macular hole surgery with internal limiting membrane removal using low-concentration indocyanine green. Retina. 2007;27:477-482.
3. Park DW, Sipperley JO, Sneed SR, Dugel PU, Jacobsen J. Macular hole surgery with internal-limiting membrane peeling and intravitreous air. Ophthalmology. 1999;106:1392-1398.
4. Wolf S, Reichel MB, Wiedemann P, Schnurrbusch UE. Clinical findings in macular hole surgery with indocyanine green–assisted peeling of the internal limiting membrane. Graefes Arch Clin Exp Ophthalmol. 2003;241:589-592.
5. Velez-Montoya R, Ramirez-Estudillo JA, Sjoholm-Gomez de Liano C, et al. Inverted ILM flap, free ILM flap and conventional ILM peeling for large macular holes. Int J Retina Vitreous. 2018;4:8.
6. Kannan NB, Kohli P, Parida H, Adenuga OO, Ramasamy K. Comparative study of inverted internal limiting membrane (ILM) flap and ILM peeling technique in large macular holes: a randomized-control trial. BMC Ophthalmol. 2018;18(1):177.
7. Michalewska Z, Michalewski J, Adelman RA, et al. Inverted internal limiting membrane flap technique for large macular holes. Ophthalmology. 2010;117(10):2018-2025.
8. Morizane Y, Shiraga F, Kimura S, et al. Autologous transplantation of ILM for refractory macular holes. Am J Ophthalmol. 2014;157(4):861-869.
9. Chen SN, Yang CM. Lens capsular flap transplantation in the management of refractory macular hole from multiple etiologies. Retina. 2016;36(1):163-170.
10. Grewal DS, Mahmoud TH. Autologous neurosensory retinal free flap for closure of refractory myopic macular holes. JAMA Ophthalmol. 2016;134(2):229-230.























